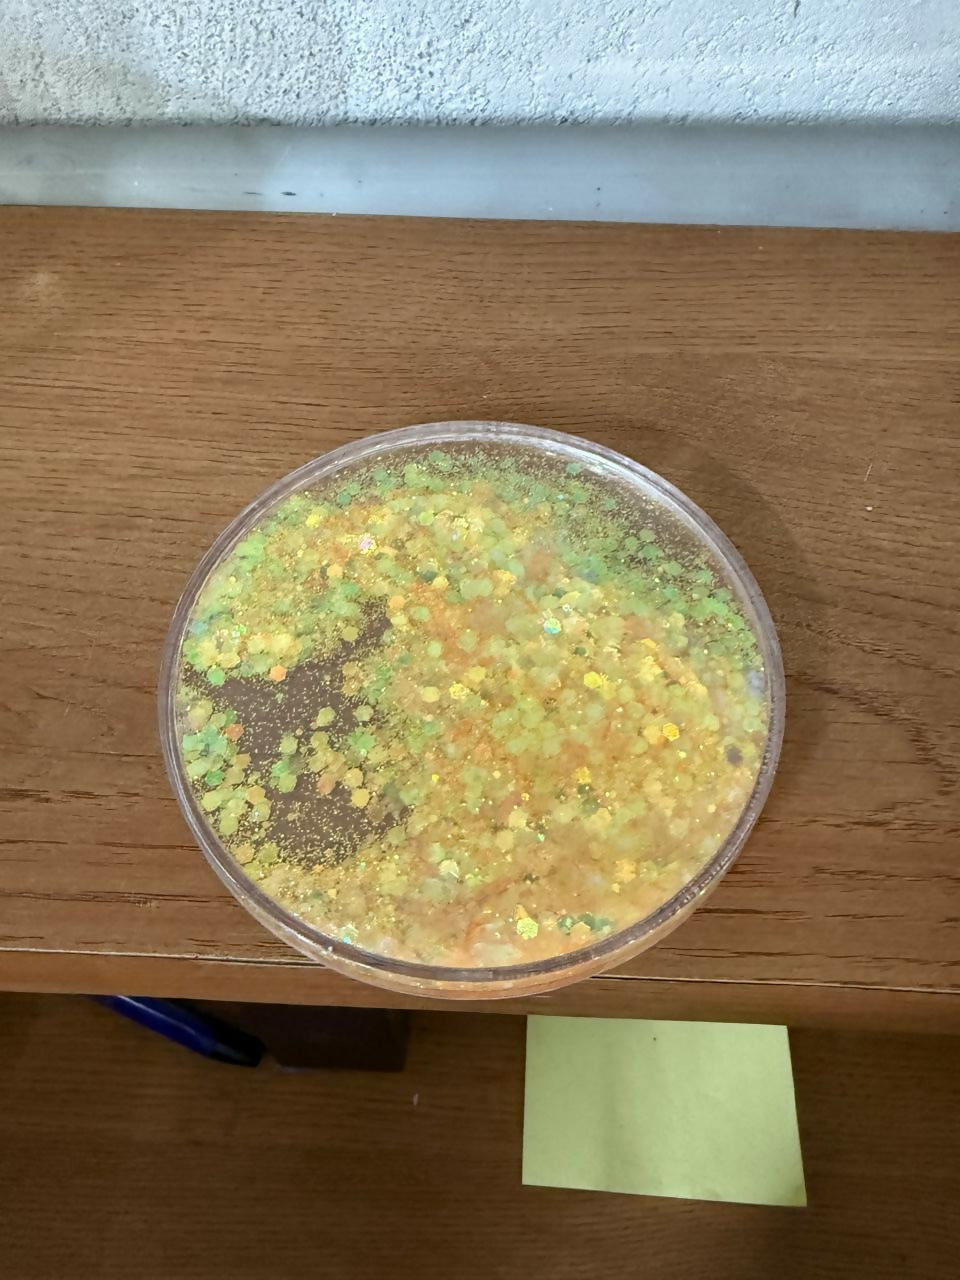
Yellow Glitter Resin Tea Coaster for Cup & Mug ( MUG NOT INCLUDED)

Yellow Glitter Resin Tea Coaster for Cup & Mug ( MUG NOT INCLUDED)
SKU whl175_71609_7077_1_ye
Couldn't load pickup availability
Order Today
Order Ready
Delivered
Share
Description
Description
Enhance your tea and coffee moments with this handcrafted glitter resin tea coaster, designed to protect your table while adding a touch of elegance. Made from high-quality resin with embedded glitter, this coaster is heat resistant, durable, and visually appealing.
Its smooth glossy finish and anti-slip base help prevent water rings, heat marks, and scratches on your dining table, office desk, or coffee table. Ideal for everyday use as well as gifting, this decorative coaster suits tea cups, coffee mugs, glass cups, and tumblers.
⭐ KEY FEATURES
Premium Resin Build – Strong, durable & long-lasting
Heat Resistant – Protects surfaces from hot cups & mugs
Anti-Slip Base – Prevents sliding and spills
Glossy Glitter Finish – Decorative and modern look
Table Protection – Avoids water stains, rings & scratches
Easy Maintenance – Wipe clean with a damp cloth
Multi-Purpose Use – Suitable for tea, coffee, juice & glassware
Perfect Gift – Ideal for housewarming, birthdays & festive gifting
tea coasterresin tea coasterglitter coastercup coastercoffee mug coastertable coasterheat resistant coasteranti slip coasterdecorative coastercoaster for tea cupresin drink coasterhome decor coasterCountry Of Origin :- China
GST :- 18%

Customers who bought this item also bought
Recently Viewed Products
Categories
- Just Arrived
- Best Seller
Shop By
Health & Personal Care
Home & Kitchen
Home Improvement
Jewellery
Office Products
Toys & Games
More
Help & More
Help
Contact Us
Care@deodap.com
- Choosing a selection results in a full page refresh.
- Opens in a new window.



















